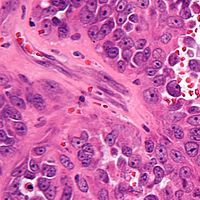

Pediatric Oncology
Latest News
Latest Videos

More News

Birte Wistinghausen, MD, associate professor, Pediatrics, medical director of the Division of Pediatric Hematology-Oncology, the Kravis Children's Hospital and Icahn School of Medicine at Mount Sinai, discusses targeted therapies for the treatment of pediatric patients with non-Hodgkin lymphoma.

The FDA has granted a priority review to a supplemental new drug application for eltrombopag (Promacta) for use in combination with standard immunosuppressive therapy as a frontline treatment for patients with severe aplastic anemia.

Susan N. Chi, MD, discusses the rationale for using tazemetostat in pediatric patients with INI1-negative rhabdoid tumors, as well as the future steps being taken with this treatment.

The FDA has granted crizotinib a breakthrough therapy designation for the treatment of patients with metastatic non–small cell lung cancer with MET exon 14 alterations, and for use in patients with relapsed/refractory ALK+ anaplastic large cell lymphoma.

Lindsay Frazier, MD, institute physician, Pediatric Hematology/Oncology, Dana-Farber Cancer Institute, associate professor of pediatrics, Harvard Medical School, discusses the Malignant Germ Cell International Consortium (MaGIC) in pediatric and rare tumors.

The FDA has granted a priority review to a new drug application for larotrectinib for the treatment of adult and pediatric patients with locally advanced or metastatic solid tumors with an NTRK gene fusion.

Birte Wistinghausen, MD, shares her insight on the potential for targeted therapies in the treatment of pediatric non-Hodgkin lymphoma, and the steps that the Children’s Oncology Group is taking to cure all patients with this disease.

A number of biological factors, including age at diagnosis, symptom duration at diagnosis, and HIST1H3B mutation status, are associated with survival ≥2 years in children and young adults with diffuse intrinsic pontine glioma, a brainstem malignancy with a median survival

An underlying autoimmune condition may have played a role in making a 13-year-old patient refractory to treatment for immune thrombocytopenia.

Ponatinib (Iclusig) induced a complete remission in one pediatric/adolescent patient with Philadelphia chromosome-positive acute lymphoblastic leukemia, and demonstrated promising clinical activity in another.

Tocilizumab resolved cytokine release syndrome in patients with relapsed/refractory pediatric B-cell acute lymphoblastic leukemia without reducing the efficacy of tisagenlecleucel.

Justin N. Baker, MD, chief, Division of Quality of Life and Palliative Care, attending physician, Quality of Life Service, St. Jude Children’s Research Hospital, discusses the importance of symptom management in children with cancer.

Anna Farago, MD, PhD, discusses the biology of larotrectinib, as well as the importance of genetic testing for molecular alterations like TRK in patients with locally advanced solid tumors.

James I. Geller, MD, medical director, Kidney and Liver Tumors Program, Cincinnati Children’s Hospital Medical Center, discusses renal rhabdoid tumors in pediatric patients.

Adding nelarabine to escalating-dose methotrexate induced a 4-year disease-free survival rate of 91% in a cohort of pediatric and young adult patients with newly diagnosed T-cell cancers.

Briana Patterson, MD, assistant professor, Division of Endocrinology, Aflac Cancer Center, Department of Pediatrics, Emory University School of Medicine, discusses concerns regarding the use of tyrosine kinase inhibitors in the treatment of children with chronic myeloid leukemia.

Discontinuation of tyrosine kinase inhibitor treatment may be a possibility for children with chronic myeloid leukemia and, because they could be on-treatment for decades, treatment-free remission is even more important for pediatric patients than for adults.

Eltrombopag (Promacta) boosted the platelet count in a 13-year-old boy with HIV-associated thrombocytopenia, according to case study results presented at the 2018 American Society of Pediatric Hematology/Oncology Conference.

Tazemetostat demonstrated promising antitumor activity in pediatric patients with INI1-negative solid tumors.

Adolescent and young adult patients with cancer placed a high importance on prognostic information, and obtaining that knowledge was associated with improved well-being.

The FDA has halted enrollment on clinical trials of tazemetostat in patients with various solid tumors and hematologic malignancies.

A novel risk stratification and treatment approach led to enhanced clinical outcomes overall, as well as the successful omission of radiotherapy for some patients with stage IV favorable histology Wilms tumor and pulmonary metastases.

Ramamoorthy Nagasubramanian, MD, discusses the results of the phase I/II study of larotrectinib in pediatric patients.

Larotrectinib induced an “unprecedented” objective response rate of 93% in patients with TRK fusion–positive solid tumors.

A rolling new drug application has been completed for larotrectinib (LOXO-101) for the treatment of adult and pediatric patients with locally advanced or metastatic solid tumors harboring an NTRK gene fusion.